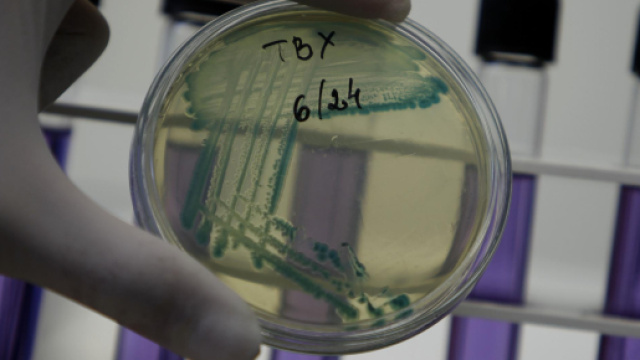
Universit&agrave; Federico II: nuovi antibiotici contro i batteri farmaco-resistenti

Fino a pochi mesi fa l'OMS aveva allertato la comunità scientifica sui troppi casi di batteri resistenti agli antibiotici e ai farmaci antimicrobici. Recentemente, invece, un'importante scoperta, coordinata da alcuni studiosi dell'Università Federico II di Napoli e de la Fuente-Nunez del MIT, ha messo in evidenza come un semplice enzima-proteina che normalmente aiuta la digestione riuscirebbe a creare naturalmente gli antibiotici utili per l'uomo. Queste molecole, presenti nell'organismo umano, sarebbero in grado di uccidere batteri, come la Salmonella e gli Escherichia Coli, e a combattere quelli resistenti ai tradizionali farmaci.
Protagonista di questa ricerca anche l'Istituto di Ricerca e Diagnostica Nucleare (IRCCS) e l'Università Luigi Vanvitelli di Caserta. Secondo questi ultimi gli antibiotici tradizionali sono ormai superati ed inefficaci: i batteri presenti nel nostro corpo hanno imparato a convivere con queste sostanze esterne prodotte artificialmente. L'obiettivo dei ricercatori è stato quello di cercare di sviluppare una nuova tecnologia in cui i batteri non sapessero "difendersi" da determinate molecole.
Antibiotici: nuove arme contro i batteri resistenti ai farmaci
Scienziati, biologi e chimici si stanno concentrando su alcune sostanze prodotte dall'uomo che sono in grado di difendere il sistema immunitario e quindi a respingere le infezioni.
Come creare degli antibiotici in grado di combattere i batteri resistenti ai farmaci tradizionali? I ricercatori protagonisti della ricerca dichiarano che bisogna prima di tutto individuare e "potenziare" quelle molecole presenti nell'organismo umano che riescono a combattere i batteri. Dopo di che, affermano gli studiosi della Fuente-Nunez, bisogna iniziare ad utilizzare la biologia sintetica per modificare e rendere più potenti le suddette molecole. Per individuarle e selezionarle i ricercatori hanno messo a punto un innovativo software che velocizza il processo sopra descritto: sono già state identificate ben 800 molecole, tra enzimi e proteine. Una di queste molecole, normalmente presente nello stomaco e che aiuta la digestione, sarebbe in grado di neutralizzare ben tre tipi di batteri, come la Salmonella, E.coli e la Pseudomonas Aeruginosa. I ricercatori hanno dichiarato che attualmente si stanno concentrando sulla proteina digestiva appena studiata, sostenendo che potrebbe diventare la base da cui ottenere nuovi antibiotici.